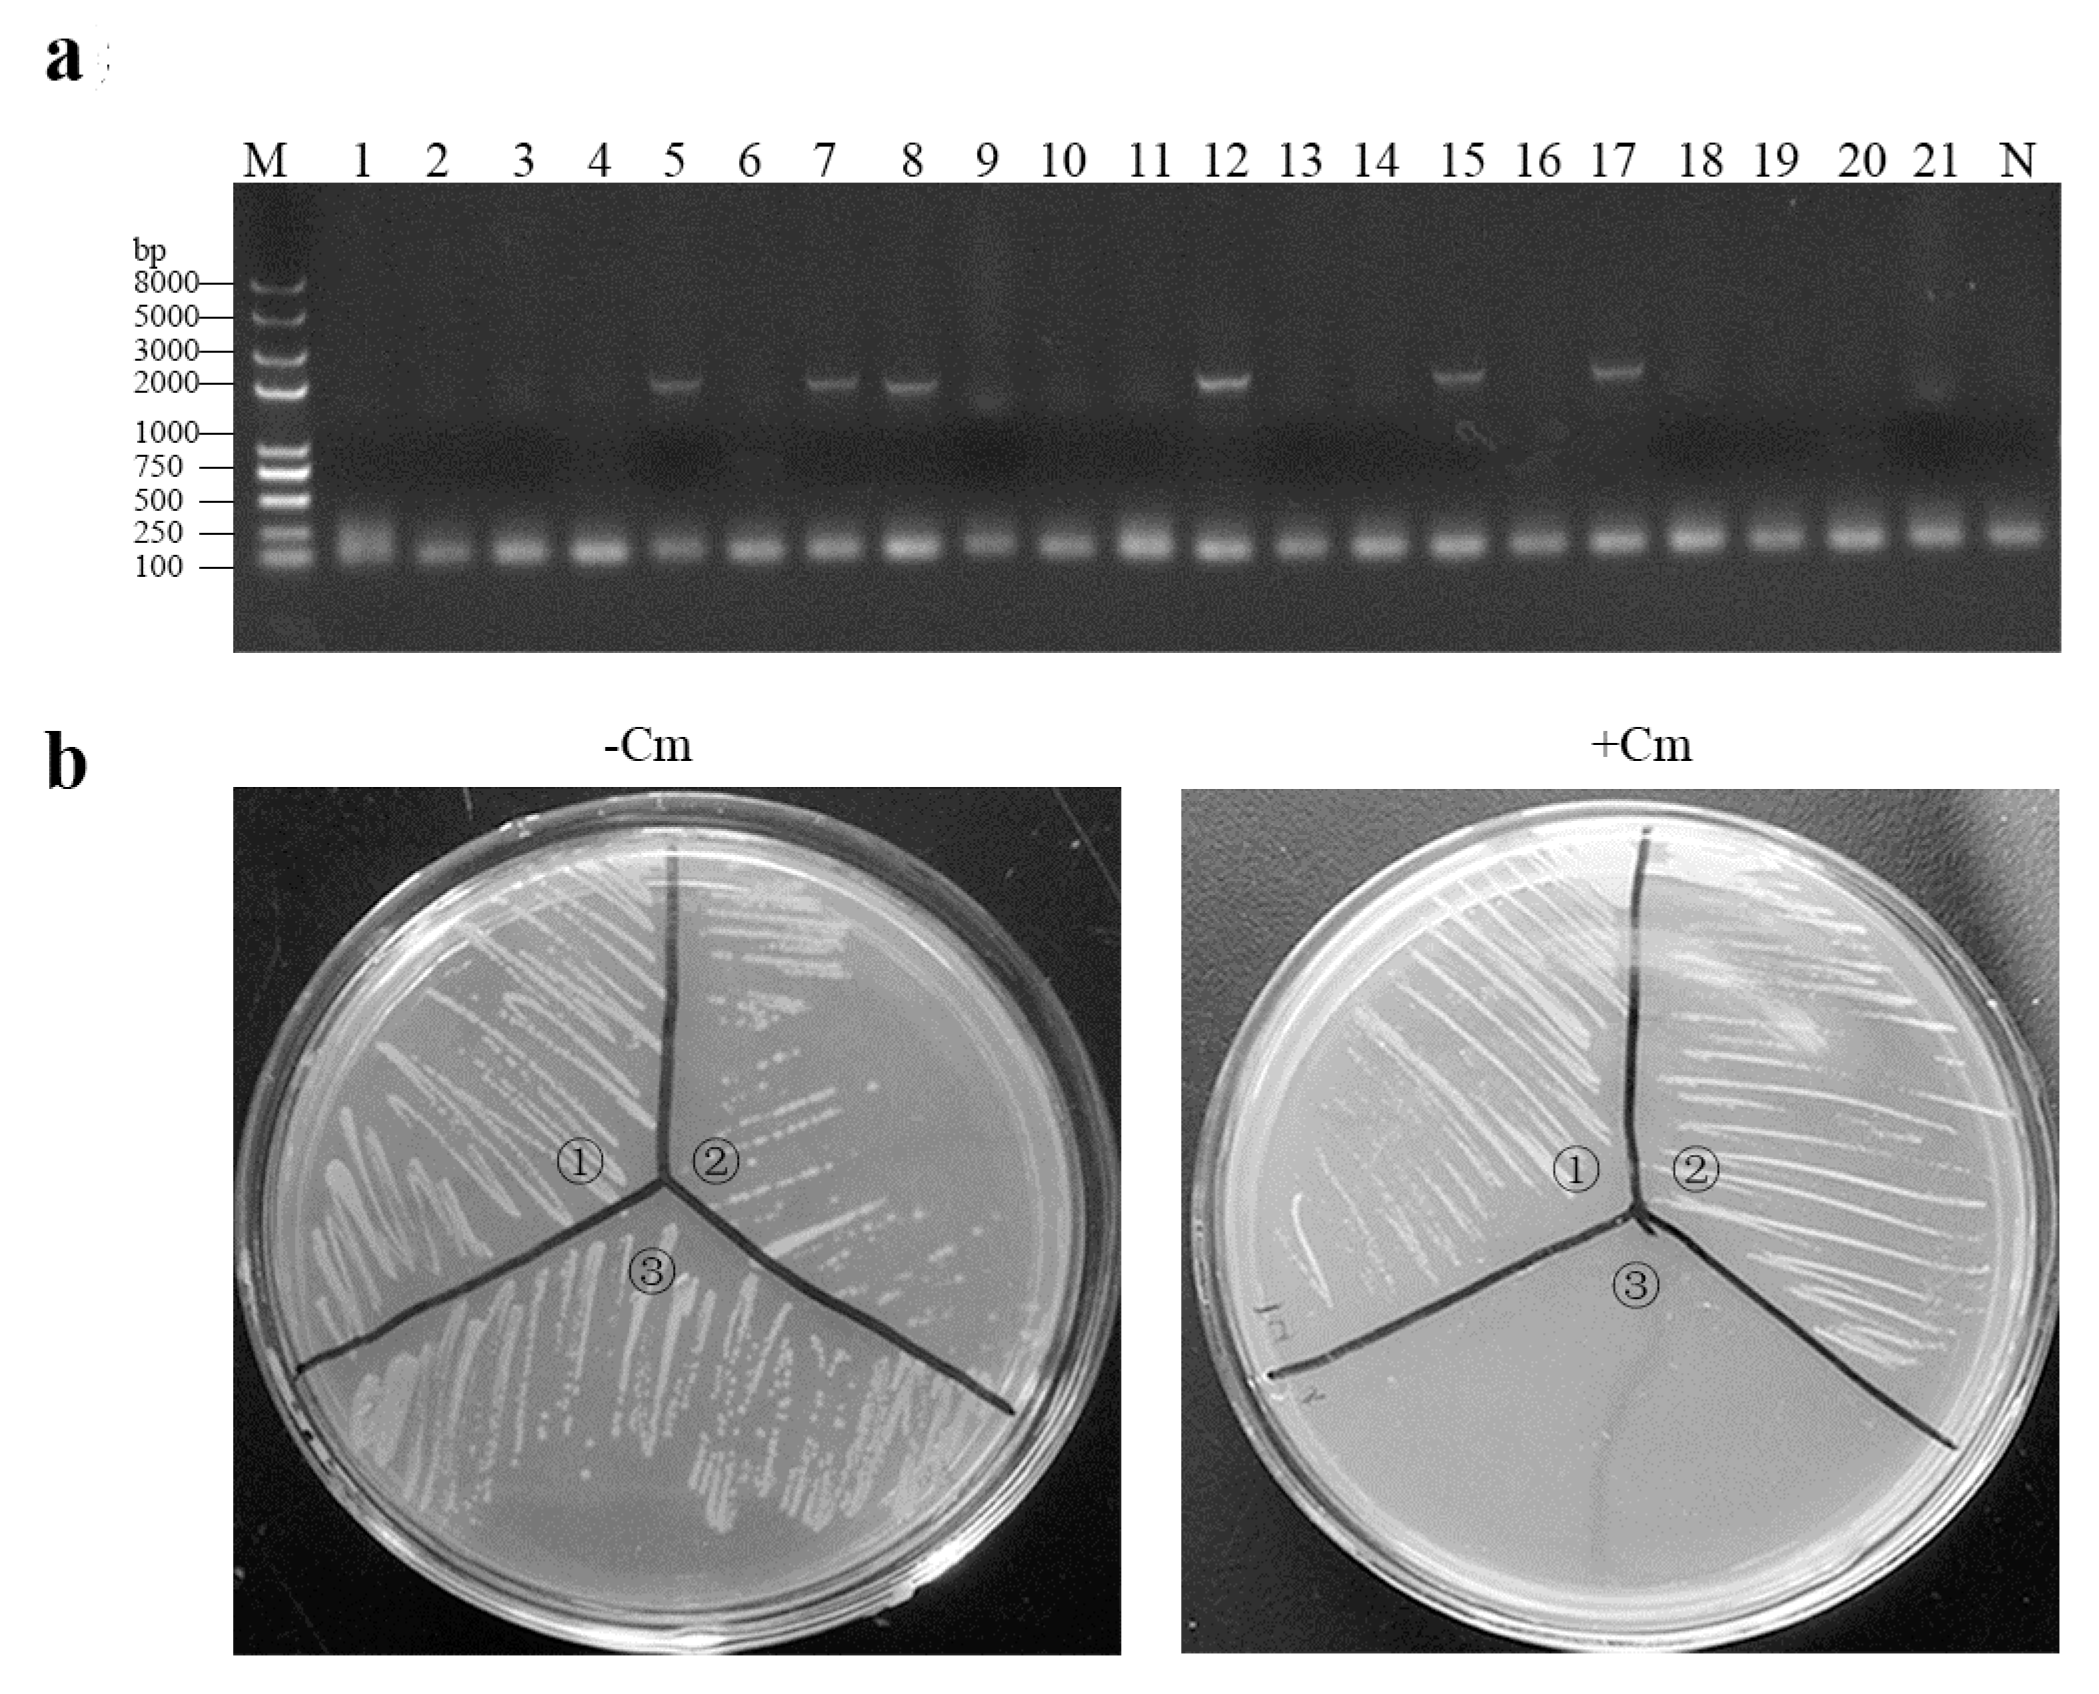
Viruses 09 00274 g002 550

Immunogenicity of eGFP-Marked Recombinant Lactobacillus casei against Transmissible Gastroenteritis Virus and Porcine Epidemic Diarrhea Virus
Abstract
:1. Introduction
2. Materials and Methods
2.1. Virus, Plasmid, Bacterium, and Cell Lines
2.2. Construction of the eGFP-Marked Recombinant Lactobacillus Strain
2.3. Identification of Proteins Expressed by the Recombinant Strain
2.4. Immunizations
2.5. ELISA Assay
2.6. TGEV and PEDV Neutralization by Mouse Immune Sera
2.7. Antigen-Induced Proliferation of Lymphocytes In Vitro
2.8. Statistical Analysis
3. Results
3.1. Construction of eGFP-Marked Recombinant Lactobacillus Strain
3.2. Expression of Proteins of Interest by Recombinant Lactobacillus Strain
3.3. Immune Responses in Mice Induced by Recombinant Lactobacillus Strain
3.4. TGEV and PEDV Neutralization
3.5. Lymphocyte Proliferation
4. Discussion
5. Conclusions
Acknowledgments
Author Contributions
Conflicts of Interest
References
- Spaan, W.; Cavanagh, D.; Horzinek, M.C. Coronaviruses: Structure and genome expression. J. Gen. Virol. 1988, 69, 2939–2952. [Google Scholar] [CrossRef] [PubMed]
- Doyle, L.P.; Hutchings, L.M. A transmissible gastroenteritis in pigs. J. Am. Vet. Med. Assoc. 1946, 108, 257–259. [Google Scholar] [PubMed]
- Pensaert, M.; Callebaut, P.; Vergote, J. Isolation of a porcine respiratory, non-enteric coronavirus related to transmissible gastroenteritis. Vet. Q. 1986, 8, 257–261. [Google Scholar] [CrossRef] [PubMed]
- Sasahara, J.; Harada, K.; Hayashi, S.; Watanabe, M. Studies on transmissible gastroenieritis in pig in Japan. Vet. Sci. 1958, 20, l–6. [Google Scholar]
- Lee, S.; Lee, C. Outbreak-related porcine epidemic diarrhea virus strains similar to US strains, South Korea, 2013. Emerg. Infect. Dis. 2014, 20, 1223–1226. [Google Scholar] [CrossRef] [PubMed]
- Mole, B. Deadly pig virus slips through US borders. Nature 2013, 499, 388. [Google Scholar] [CrossRef] [PubMed]
- Van Diep, N.; Norimine, J.; Sueyoshi, M.; Lan, N.T.; Hirai, T.; Yamaguchi, R. US-like isolates of porcine epidemic diarrhea virus from Japanese outbreaks between 2013 and 2014. Springerplus 2015, 4, 756. [Google Scholar] [CrossRef] [PubMed]
- Boniotti, M.B.; Papetti, A.; Lavazza, A.; Alborali, G.; Sozzi, E.; Chiapponi, C.; Faccini, S.; Bonilauri, P.; Cordioli, P.; Marthaler, D. Porcine epidemic diarrhea virus and discovery of a recombinant swine enteric coronavirus, Italy. Emerg. Infect. Dis. 2016, 22, 83–87. [Google Scholar] [CrossRef] [PubMed]
- Chen, J.; Liu, X.; Shi, D.; Shi, H.; Zhang, X.; Li, C.; Chi, Y.; Feng, L. Detection and molecular diversity of spike gene of porcine epidemic diarrhea virus in China. Viruses 2013, 5, 2601–2613. [Google Scholar] [CrossRef] [PubMed]
- Chiou, H.Y.; Huang, Y.L.; Deng, M.C.; Chang, C.Y.; Jeng, C.R.; Tsai, P.S.; Yang, C.; Pang, V.F.; Chang, H.W. Phylogenetic analysis of the spike (S) gene of the new variants of porcine epidemic diarrhoea virus in Taiwan. Transbound. Emerg. Dis. 2017, 64, 157–166. [Google Scholar] [CrossRef] [PubMed]
- Vlasova, A.N.; Marthaler, D.; Wang, Q.H.; Culhane, M.R.; Rossow, K.D.; Rovira, A.; Collins, J.; Saif, L.J. Distinct characteristics and complex evolution of PEDV strains, North America, may 2013–February. Emerg. Infect. Dis. 2014, 20, 1620–1628. [Google Scholar] [CrossRef] [PubMed]
- Jiang, X.P.; Hou, X.Y.; Tang, L.J.; Jiang, Y.P.; Ma, G.P.; Li, Y.J. A phase trial of the oral Lactobacillus casei vaccine polarizes Th2 cell immunity against transmissible gastroenteritis coronavirus infection. Appl. Microbiol. Biotechnol. 2016, 100, 7457–7469. [Google Scholar] [CrossRef] [PubMed]
- Wang, X.L.; Wang, Z.B.; Xu, H.Y.; Xiang, B.; Dang, R.Y.; Yang, Z.Q. Orally administrated whole yeast vaccine against porcine epidemic diarrhea virus induced high levels of IgA response in mice and piglets. Viral Immunol. 2016, 29, 526–531. [Google Scholar] [CrossRef] [PubMed]
- Bohl, E.H.; Gupta, R.K.; Olquin, M.V.; Saif, L.J. Antibody responses in serum, colostrum, and milk of swine after infection or vaccination with transmissible gastroenteritis virus. Infect. Immun. 1972, 6, 289–301. [Google Scholar] [PubMed]
- Mutwiri, G.; Watts, T.; Lew, L.; Beskorwayne, T.; Papp, Z.; Bace-estrada, M.E.; Griebel, P. Ileal and jejunal Peyer’s patches play distinct roles in mucosal immunity of sheep. Immunology 1999, 97, 455–461. [Google Scholar] [CrossRef] [PubMed]
- Song, D.S.; Oh, J.S.; Kang, B.K.; Yang, J.S.; Moon, H.J.; Yoo, H.S.; Jang, Y.S.; Park, B.K. Oral efficacy of Vero cell attenuated porcine epidemic diarrhea virus DR13 strain. Res. Vet. Sci. 2007, 82, 134–140. [Google Scholar] [CrossRef] [PubMed]
- Song, D.; Moon, H.; Kang, B. Porcine epidemic diarrhea: A review of current epidemiology and available vaccines. Clin. Exp. Vaccine Res. 2015, 4, 166–176. [Google Scholar] [CrossRef] [PubMed]
- Ge, J.W.; Liu, D.Q.; Li, Y.J. Construction of recombinant lactobacilli expressing the core neutralizing epitope (COE) of porcine epidemic diarrhea virus and a fusion protein consisting of COE and Escherichia coli heat-labile enterotoxin B, and comparison of the immune responses by orogastric immunization. Can. J. Microbiol. 2012, 58, 1258–1267. [Google Scholar] [PubMed]
- Posthumus, W.P.; Lenstra, J.A.; Schaaper, W.M.; van Nieuwstadt, A.P.; Enjuanes, L.; Meloen, R.H. Analysis and simulation of a neutralizing epitope of transmissible gastroenteritis virus. J. Virol. 1990, 64, 3304–3309. [Google Scholar] [PubMed]
- Seegers, J.F. Lactobacilli as live vaccine delivery vectors: Progress and prospects. Trends Biotechnol. 2002, 20, 508–515. [Google Scholar] [CrossRef]
- Yu, M.L.; Qi, R.M.; Chen, C.Y.; Yin, J.Y.; Ma, S.T.; Shi, W.; Wu, Y.; Ge, J.W.; Jiang, Y.P.; Tang, L.J.; et al. Immunogenicity of recombinant Lactobacillus casei expressing F4 (K88) fimbrial adhesin FaeG in conjunction with a heat-labile enterotoxin A (LTAK63) and heat-labile enterotoxin B (LTB) of enterotoxigenic Escherichia coli as an oral adjuvant in mice. J. Appl. Microbiol. 2017, 122, 506–515. [Google Scholar] [CrossRef] [PubMed]
- Zhang, N.; Hou, X.; Yu, L.; Wang, G.; Zhao, Z.; Gao, Y. Colonization and distribution of recombinant Lactobacillus casei with green fluorescent protein in mice intestine. Wei Sheng Wu Xue Bao 2010, 50, 1232–1238. [Google Scholar] [PubMed]
- Xu, Y.G.; Cui, L.C.; Tian, C.Y.; Zhang, G.C.; Huo, G.C.; Tang, L.J.; Li, Y.J. Immunogenicity of recombinant classic swine fever virus CD8 (+) T lymphocyte epitope and porcine parvovirus VP2 antigen coexpressed by Lactobacillus casei in swine via oral vaccination. Clin. Vaccine Immunol. 2011, 18, 1979–1986. [Google Scholar] [CrossRef] [PubMed]
- Meng, F.D.; Ren, Y.D.; Suo, S.; Sun, X.J.; Li, X.L.; Li, P.C.; Yang, W.; Li, G.X.; Li, L.; Schwegmann-Wessels, C.; et al. Evaluation on the efficacy and immunogenicity of recombinant DNA plasmids expressing spike genes from porcine transmissible gastroenteritis virus and porcine epidemic diarrhea virus. PLoS ONE 2013, 8, e57468. [Google Scholar] [CrossRef] [PubMed]
- Walsh, C.; Walsh, C. Antibiotics: Actions, origins, resistance. Nat. Prod. Rep. 2005, 22, 304–305. [Google Scholar]
- Zhang, Y.; Zhang, X.; Liao, X.; Huang, X.; Cao, S.; Wen, X.; Wen, Y.; Wu, R.; Liu, W. Construction of a bivalent DNA vaccine co-expressing S genes of transmissible gastroenteritis virus and porcine epidemic diarrhea virus delivered by attenuated Salmonella typhimurium. Virus Genes 2016, 52, 354–364. [Google Scholar] [CrossRef] [PubMed]
- Elliott, D.A.; Braam, S.R.; Koutsis, K.; Ng, E.S.; Jenny, R.; Lagerqvist, E.L.; Biben, C.; Hatzistavrou, T.; Hirst, C.E.; Yu, Q.C.; et al. NKX2-5(eGFP/w) hESCs for isolation of human cardiac progenitors and cardiomyocytes. Nat. Methods 2011, 8, 1037–1040. [Google Scholar] [CrossRef] [PubMed]
- Kemter, E.; Cohrs, C.M.; Schäfer, M.; Schuster, M.; Steinmeyer, K.; Wolf-van, B.L.; Wolf, A.; Wuensch, A.; Kurome, M.; Kessler, B.; et al. INS-eGFP transgenic pigs: A novel reporter system for studying maturation, growth and vascularisation of neonatal islet-like cell clusters. Diabetologia 2017, 60, 1152–1156. [Google Scholar] [CrossRef] [PubMed]
- Li, Y.J.; Zhang, B.; Tang, L.J.; Jiang, Y.P.; Chen, P.P. Genetic variation analysis of S1 genes of PEDV endemic strains and immunogenicity detection of HLJ-2012 strain. J. Northeast Agric. Univ. 2014, 45, 1–9. [Google Scholar]
- Ren, X.F.; Li, Y.J.; Liu, B.Q. Cloning and homology comparison of S gene for isolate TH-98 of porcine transmissible gastroenteritis virus. Agric. Sci. China 2002, 2, 314–320. [Google Scholar]
- Liu, D.Q.; Qiao, X.Y.; Ge, J.W.; Tang, L.J.; Jiang, Y.P.; Li, Y.J. Construction and characterization of Lactobacillus pentosus expressing the D antigenic site of the spike protein of transmissible gastroenteritis virus. Can. J. Microbiol. 2011, 57, 392–397. [Google Scholar]
- Wang, C.; Lian, G.H.; Zhao, L.L.; Wu, Y.; Li, Y.J.; Tang, L.J.; Qiao, X.Y.; Jiang, Y.P.; Liu, M. Virulence and serological studies of recombinant infectious hematopoietic necrosis virus (IHNV) in rainbow trout. Virus Res. 2016, 220, 193–202. [Google Scholar] [CrossRef] [PubMed]
- Song, B.F.; Ju, L.Z.; Li, Y.J.; Tang, L.J. Chromosomal insertions in the Lactobacillus casei upp gene that are useful for vaccine expression. Appl. Environ. Microbiol. 2014, 80, 3321–3326. [Google Scholar] [CrossRef] [PubMed]
- Jiang, X.P.; Yu, M.L.; Qiao, X.Y.; Liu, M.; Tang, L.J.; Jiang, Y.P.; Cui, W.; Li, Y.J. Up-regulation of MDP and tuftsin gene expression in Th1 and Th17 cells as an adjuvant for an oral Lactobacillus casei vaccine against anti-transmissible gastroenteritis virus. Appl. Microbiol. Biotechnol. 2014, 98, 8301–8312. [Google Scholar] [CrossRef] [PubMed]
- Robinson, K.; Chamberlain, L.M.; Schofield, K.M.; Wells, J.M.; Le Page, R.W. Oral vaccination of mice against tetanus with recombinant Lactococcus lactis. Nat. Biotechnol. 1997, 15, 653–657. [Google Scholar] [CrossRef] [PubMed]
- Shi, W.; Jia, S.; Zhao, H.Y.; Yin, J.Y.; Wang, X.N.; Yu, M.L.; Ma, S.T.; Wu, Y.; Chen, Y.; Fan, W.L.; et al. Novel approach for isolation and identification of porcine epidemic diarrhea virus (PEDV) strain NJ using porcine intestinal epithelial cells. Viruses 2017, 9, 19. [Google Scholar] [CrossRef] [PubMed]
- Ashiuchi, M.; Nawa, C.; Kamei, T.; Song, J.J.; Hong, S.P.; Sung, M.H.; Soda, K.; Misono, H. Physiological and biochemical characteristics of poly gamma-glutamate synthetase complex of Bacillus subtilis. Eur. J. Biochem. 2001, 268, 5321–5328. [Google Scholar] [CrossRef] [PubMed]
- Van, B.J.; Blohmke, C.J.; Folkerts, H.; de Boer, R.; Zakrzewska, A.; Kulik, W.; Vaz, F.M.; Brul, S.; Ter Beek, A. RodZ and PgsA play intertwined roles in membrane homeostasis of Bacillus subtilis and resistance to weak organic acid stress. Front. Microbiol. 2016, 7, 1633. [Google Scholar] [CrossRef]

| Plasmids | Relevant Characteristics | Description/Reference |
|---|---|---|
| pMD18-T-6D | As a template for PCR to amplify DNA fragment 6D | Liu et al. 2011 [31] |
| peGFP-N1 | As a template for PCR to amplify DNA fragment eGFP | Wang et al. 2016 [32] |
| pMD18-T-COE | 3169 bp; Ampr; core neutralizing epitope (COE) of PEDV strain HLJ-2012 | This study |
| pMD19-Ts | 2692 bp; Ampr | Takara (DaLian, China) |
| pMD19-Ts-6D | 3325 bp; Ampr; the amplified DNA fragment 6D was inserted into pMD19-Ts | This study |
| pMD19-Ts-eGFP | 3469 bp; Ampr; the amplified DNA fragment eGFP was inserted into pMD19-Ts | This study |
| pMD18-T-6D-COE | 3766 bp; Ampr; 6D was inserted into pMD18-T-COE | This study |
| pPG-T7g10 | 4965 bp; Cmr; HCE promoter of Geobacillus toebii D-AAT; poly-γ-glutamate synthase A (PgsA) anchor; constitutive expression plasmid | Song et al., 2014 [33] |
| pPG-T7g10-6D-COE | 6034 bp; Cmr; 6D-COE was inserted into pPG-T7g10 | This study |
| pPG-T7g10-eGFP-6D-COE | 6793 bp; Cmr; eGFP was inserted into pPG-T7g10-6D-COE | This study |
| pPGF-T7g10-eGFP-6D-COE | 6596 bp; Cmr gene of pPG-T7g10-eGFP-6D-COE was deleted | This study |
| Gene | ID | Primer Sequences | Length(bp) | Accession No./Reference |
|---|---|---|---|---|
| 6D | Fs1 | 5′-GAGCTCGCAGGTACCAGATCTTGTT-3′ | 612 | Liu et al., 2011 [31] |
| Rs1 | 5′-ACGCGTGAGTCTAGAGGATCCGCCAC-3′ | |||
| COE | Fs2 | 5′-ACGCGTGGTGGAGGAGGTTCAGGCGGAGGTGGCTCTGGCGGTGGCGGATCGGTTACTTTGCCATCATTT-3′ | 420 | JX512907 |
| Rs2 | 5′-GGGCCCAACGTCCGTGACACCTTC-3′ | |||
| eGFP | Fe | 5′-CGAGCTCATGGTGAGCAAGGGCGA-3′ | 720 | U55762.1 |
| Re | 5′-GGGGTACCCGATCCGCCACCGCCAGAGCCACCTCCGCCTGAACCGCCTCCACCCTTGTACAGCTCGTCCATGC-3′ |
| Group | No. of Mice | Dose/Treatment | No. of Treatments |
|---|---|---|---|
| Phosphate-buffered saline (PBS) | 15 | 200 μL of PBS | 3 |
| rLpPG-T7g10 | 15 | 200 μL of 1010 CFU mL−1 | 3 |
| rLpPG-T7g10-6D-COE | 15 | 200 μL of 1010 CFU mL−1 | 3 |
| rLpPGF-T7g10-eGFP-6D-COE | 15 | 200 μL of 1010 CFU mL−1 | 3 |
© 2017 by the authors. Licensee MDPI, Basel, Switzerland. This article is an open access article distributed under the terms and conditions of the Creative Commons Attribution (CC BY) license (http://creativecommons.org/licenses/by/4.0/).
Share and Cite
Yu, M.; Wang, L.; Ma, S.; Wang, X.; Wang, Y.; Xiao, Y.; Jiang, Y.; Qiao, X.; Tang, L.; Xu, Y.; et al. Immunogenicity of eGFP-Marked Recombinant Lactobacillus casei against Transmissible Gastroenteritis Virus and Porcine Epidemic Diarrhea Virus. Viruses 2017, 9, 274. https://doi.org/10.3390/v9100274
Yu M, Wang L, Ma S, Wang X, Wang Y, Xiao Y, Jiang Y, Qiao X, Tang L, Xu Y, et al. Immunogenicity of eGFP-Marked Recombinant Lactobacillus casei against Transmissible Gastroenteritis Virus and Porcine Epidemic Diarrhea Virus. Viruses. 2017; 9(10):274. https://doi.org/10.3390/v9100274
Chicago/Turabian StyleYu, Meiling, Li Wang, Sunting Ma, Xiaona Wang, Yusai Wang, Ya Xiao, Yanping Jiang, Xinyuan Qiao, Lijie Tang, Yigang Xu, and et al. 2017. "Immunogenicity of eGFP-Marked Recombinant Lactobacillus casei against Transmissible Gastroenteritis Virus and Porcine Epidemic Diarrhea Virus" Viruses 9, no. 10: 274. https://doi.org/10.3390/v9100274
APA StyleYu, M., Wang, L., Ma, S., Wang, X., Wang, Y., Xiao, Y., Jiang, Y., Qiao, X., Tang, L., Xu, Y., & Li, Y. (2017). Immunogenicity of eGFP-Marked Recombinant Lactobacillus casei against Transmissible Gastroenteritis Virus and Porcine Epidemic Diarrhea Virus. Viruses, 9(10), 274. https://doi.org/10.3390/v9100274




